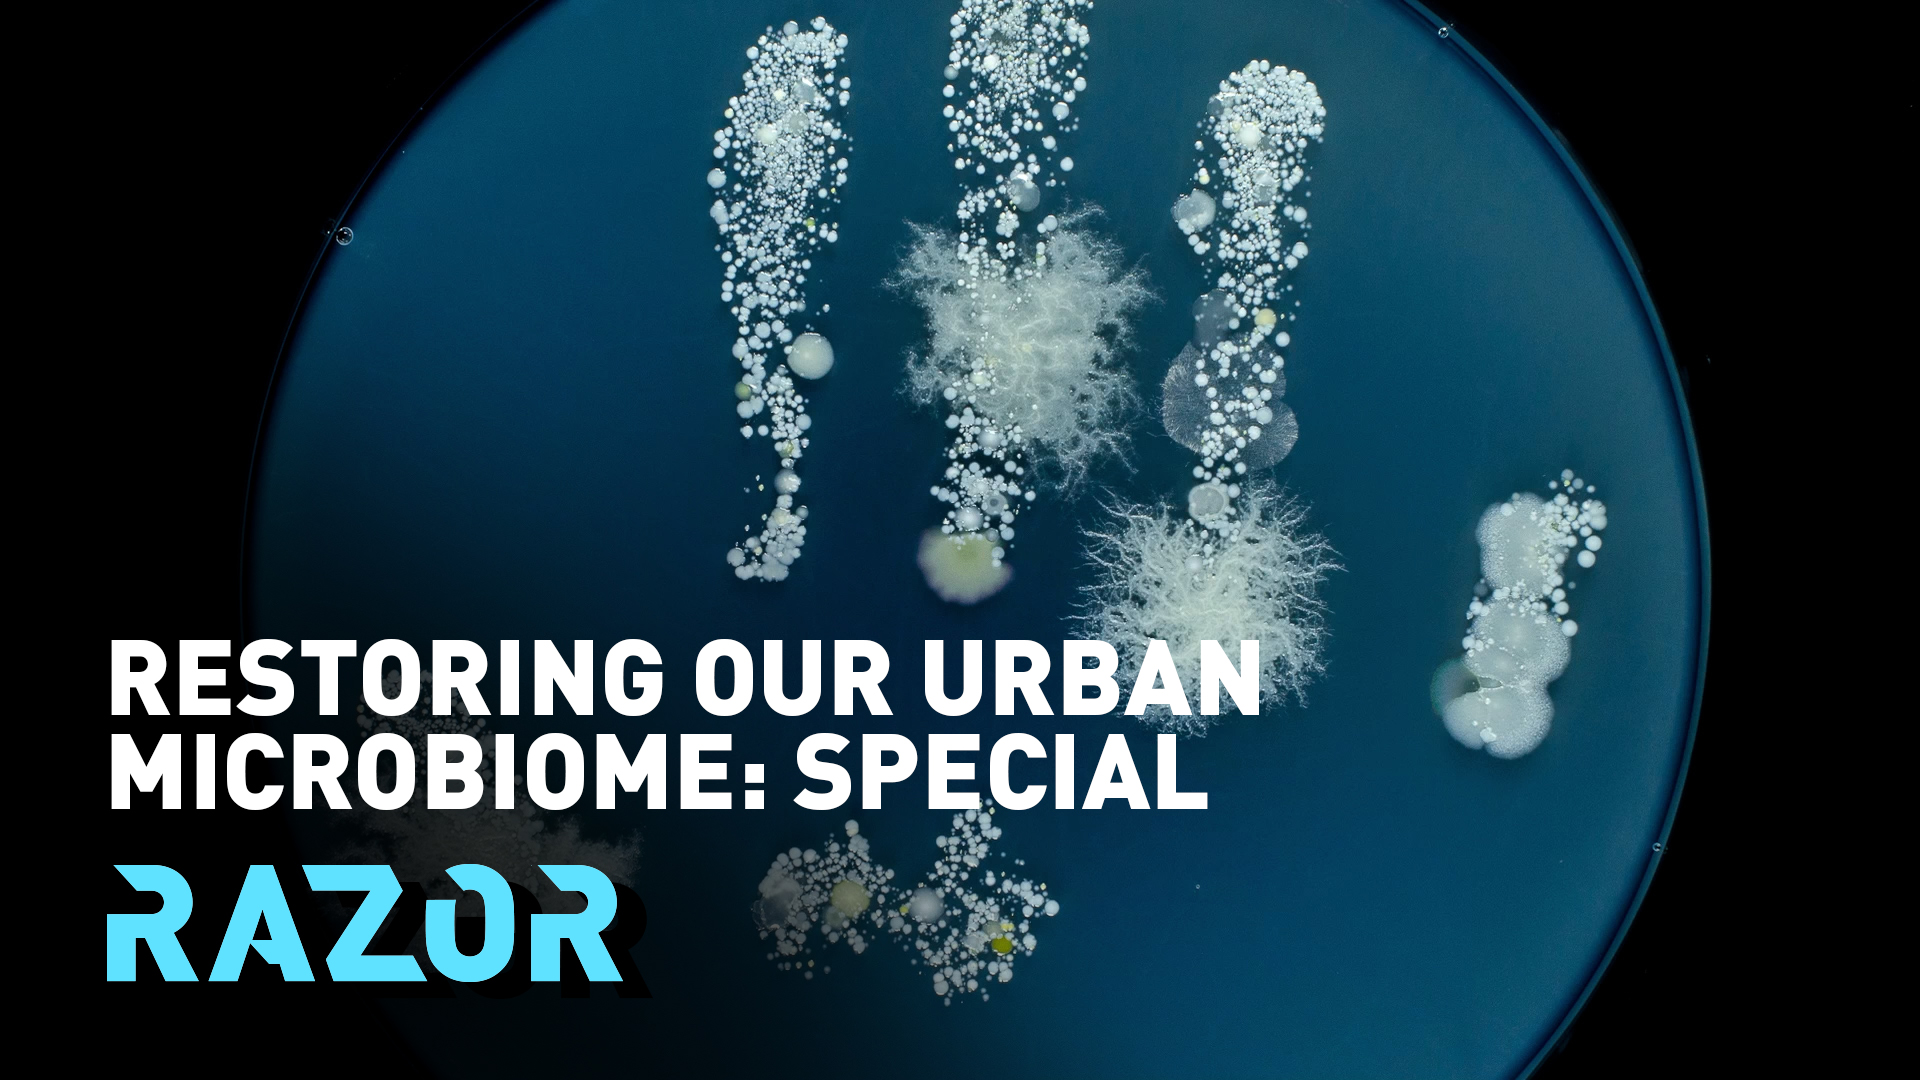

art of the zoo urban dictionary
The movement called art of the zoo is something that is. Art Of The Zoo.

Since We Re Posting These Fun Urban Dictionary Screenshots Here S A Fun 2 For 1 R Awfuleverything
A large apartment complex located in Chico CA with a reputation for outrageous parties and.

. According to Urban Dictionary if Art of the Zoo is searched on Google it explains the human is having sexual intercourse with animals images or videos pop up on the screen. Look Up B A M F In The Urban Dictionary And You Will See This Guy Elephants Photos Majestic Animals Animals Beautiful I Love Urban Dictionary R Funny. Art of the Zoo Real Meaning Art of the Zoo simply is the other phrase for Bestiality.
The nature of reality is inherently ambiguous and is. A large apartment complex located in Chico CA with a reputation for outrageous parties and debauchery by its tenants who are primarily college students. Within the zoolological community exists a cult of personality that attracts some of the most ugly frumpiest cat.
URBAN DICTIONARY is a creative content agency that creates engaging informative and entertaining content for businesses and websites. The drug users that live there are called the animals of the zoo house. Zoo York is a style and social philosophy inspired by the New York City graffiti art subculture of the 1970s.
There are numerous articles in the blog that deals with zoo. Each animal within the awkward zoo has its own awkward physical motion to make any awkward situation more awkward in hopes. Josh King Madrid better known as JetSet or JetSetFly wrote a book called The Art Of Frame Control after writing JETSET Life Hacks.
A place to purchase and smoke crack cocaine. Another word for a speedo most of the time refering to overweight men wearing speedos because it apears that your ass is eating up the speedo. The zona zooat the University of.
The Art of Zoo is a movement that started in the early 2000s when young people would take pictures of themselves with animals they captured. One of the interesting features of Urban Dictionary is the Art of Zoo section. 1the art of seperating the vagina lips and taking a shat inside and possibly having sex with it afterwards.
Art of zoo. Art of the zoo. Art of the Zoo meaning explored.
Zoo dykes is a slang term for a female zookeeper. Art of the zoo real meaning art of the zoo simply is. The movement called art of the zoo is something that is.
Short for zoophile which means one who has a deep emotional attraction to animals and may prefer them to a human as a companionsexual. The craziest and baddest official student section and student ticketing program for intercollegiate athletic events BOTH sides of the mississippi. The collection of all of the awkward animals.
According to Urban Dictionary if Art of the Zoo is searched on Google it explains the human is having. An internet meme that became famous on Reddit expecially rshitposting and rmemes if searched on google picture of bestiality will appear. This section allows users to submit photos of billboards posters or other advertisement displays that use the.
Get the zoo mug. So according to the urban dictionary art of the zoo means human beings getting sexually involved with various animals. What is the Art of Zoo meaning.
A blog about zoos and animal enthusiasts culture in the form of Art of the Zoo is being published on this platform. They live like animals where they relive. Art Of The Zoo.
Art of zoo An internet meme that became famous on Reddit expecially rshitposting and rmemes if searched on google picture of bestiality will appear Reddit user uyes_nose- me.

What Does Art Of The Zoo Mean Why It S Going Viral Market Research Telecast

Ijgi Free Full Text Functional Classification Of Urban Parks Based On Urban Functional Zone And Crowd Sourced Geographical Data Html

Art Of The Zoo On Tiktok What Is It And Why Is It Trending
Restoring Our Urban Microbiome A Razor Special Cgtn

These Are The Top 9 New Emojis You Ll Need For 2018 Vogue

Slaughterhouse Five Dictionary Definition Printable Art Etsy

Art Of The Zoo Meaning Why Is Tiktok Freaking Out About This Phrase

List Of Slang Names For Cannabis Wikipedia

The 37 Most Disgusting Urban Dictionary Definitions Ever

Pittsburgh Urban Forest Master Plan By Tree Pittsburgh Issuu

Dinosaurs In The Aquarium Ilja Nieuwland 2020
![]()
What Does Sus Mean Merriam Webster

Urban Dict A Virtual Copywriting Monstar

Restoring Our Urban Microbiome A Razor Special Cgtn

Urban Dictionary Stickers For Sale Teepublic

Stories Links Web Extras And More From Cbs News Sunday Morning Cbs News
![]()
The Zoo Definitions Meanings That Nobody Will Tell You

What Does Art Of The Zoo Mean Why It S Going Viral On Tiktok

Urban Type Any Word Dictionary Top Definition Angry Raccoon When Banging A Girl From Behind You Stick Both Your Pointer Fingers In Her Ass And When She Turns Around In Shock You